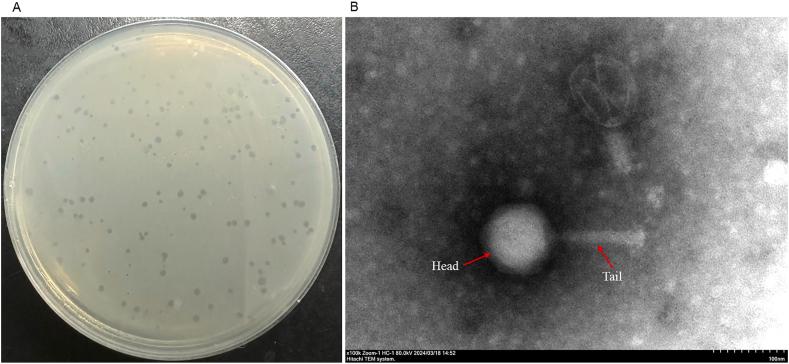
https://cdn.ncbi.nlm.nih.gov/pmc/blobs/232d/12398825/213310ed62a1/gr1.jpg

新型噬菌体CC_R7作为鸡肉生物防治剂的特性及应用
Characterization and application of a novel phage CC_R7 as a biocontrol agent in chicken meat.
作者信息
Rafiq Muhammad Shahzad, Chen Jie, Akmal Muhammad, Ma Dongxin, Asif Ali, Wang Junhao, Gu Shuaifeng, Gu Yufeng, Tao Pan, Hao Haihong
机构信息
National Key Laboratory of Agricultural Microbiology, Huazhong Agricultural University, Wuhan, China.
National Reference Laboratory of Veterinary Drug Residues, Huazhong Agricultural University, Wuhan, 430070, China.
出版信息
Curr Res Food Sci. 2025 Aug 20;11:101182. doi: 10.1016/j.crfs.2025.101182. eCollection 2025.
is a major foodborne pathogen, commonly transmitted through poultry. The emergence of multidrug-resistant strains due to antibiotic overuse in poultry farming highlights the need for monitoring resistance patterns and exploring alternative control strategies, such as bacteriophage application. This study examined the antimicrobial resistance patterns in () and (). Additionally, a novel lytic phage CC_R7 was isolated, characterized, and subjected to complete genomic analysis. The phage CC_R7 application was evaluated for biofilm removal under slaughterhouse conditions and as a biocontrol agent in chicken meat. The results showed that the resistance rate in was higher than in The phage CC_R7 has a genome size of 180,566 bp, and no virulent gene was found. It has a broad host range, killing 60 % of and 27.2 % of tested strains with excellent adsorption, a short latent period of 40 min, and a high burst size of 119 virions. The phage remained stable across temperatures (4 °C-50 °C) and pH levels (4-10). Moreover, phage CC_R7 has the potential to inhibit biofilm formation and reduce contamination in chicken meat by 1.2 log/g. Therefore, phage CC_R7 has unique characteristics to combat multidrug-resistant strains and can be used as a feed additive for biocontrol in food.
是一种主要的食源性病原体,通常通过家禽传播。由于家禽养殖中抗生素的过度使用,多重耐药菌株的出现凸显了监测耐药模式和探索替代控制策略(如噬菌体应用)的必要性。本研究检测了()和()中的抗菌耐药模式。此外,分离、鉴定了一种新型裂解性噬菌体CC_R7,并对其进行了全基因组分析。评估了噬菌体CC_R7在屠宰场条件下去除生物膜的效果以及作为鸡肉生物防治剂的作用。结果表明,()中的耐药率高于()。噬菌体CC_R7的基因组大小为180,566 bp,未发现毒性基因。它具有广泛的宿主范围,能杀死60%的()测试菌株和27.2%的()测试菌株,具有良好的吸附性、40分钟的短潜伏期和119个病毒粒子的高爆发量。该噬菌体在温度(4°C - 50°C)和pH值(4 - 10)范围内保持稳定。此外,噬菌体CC_R7有潜力抑制生物膜形成,并使鸡肉中的()污染减少1.2 log/g。因此,噬菌体CC_R7具有对抗多重耐药()菌株的独特特性,可作为食品生物防治的饲料添加剂。